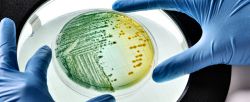
Врач-инфекционист: что лечит, какие заболевания диагностирует, когда обращаться к врачу-инфекционисту?

Агрегация сперматозоидов: что это значит, причины и лечение, последствия патологии
Если пара в течение года вела активную половую жизнь без использования предохранительных средств, но беременность так и не наступила, специалисты начинают вести речь о первичном бесплодии. Одним из первых анализов, которые сдаст мужчина, будет спермограмма. Именно с помощью нее можно будет обнаружить такое явление, как агрегация сперматозоидов. Что значит этот диагноз, каковы причины его возникновения и способы лечения, рассмотрим в данной статье.
Светлана Саксина